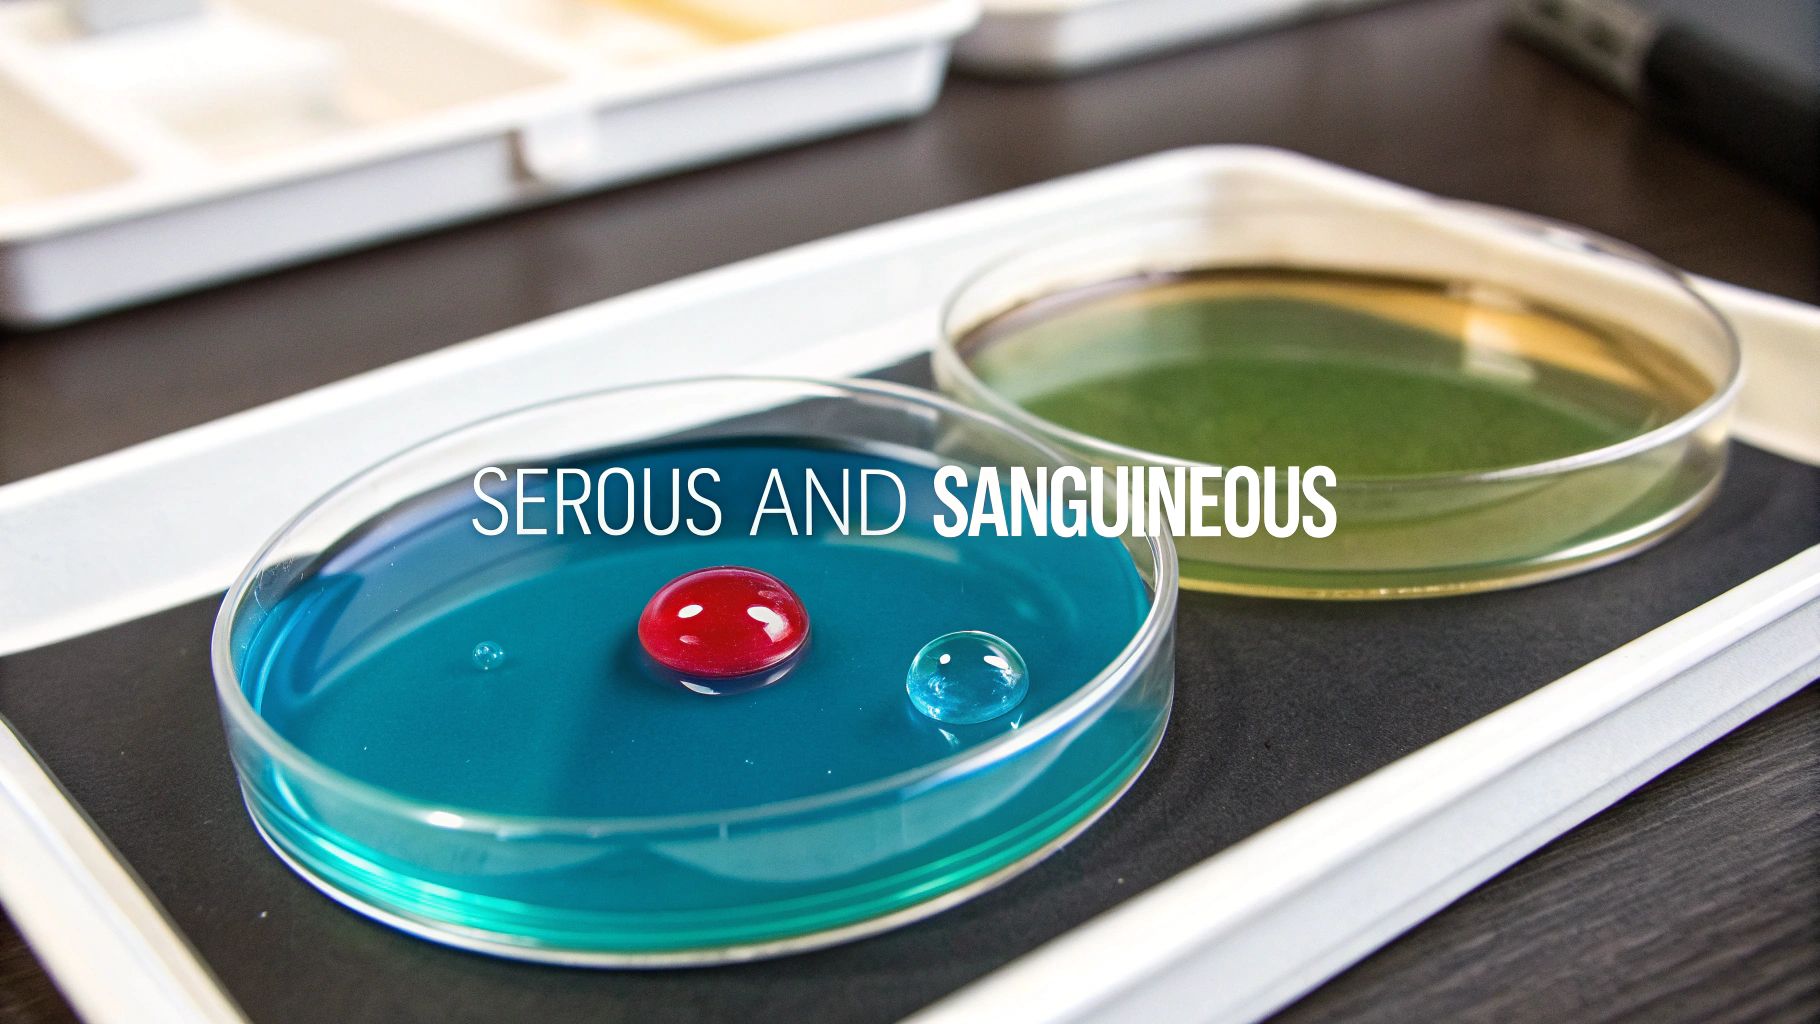
Two petri dishes with blue and green liquids, one with red and clear droplets, illustrating exudates.

Think of wound exudate as the wound’s way of talking to you. It’s not just drainage; it's a direct report from the front lines of healing. The color, consistency, volume, and odor of this fluid tell a detailed story about what’s happening beneath the surface. For clinicians, learning to interpret this "language" is a cornerstone of exceptional wound care, enabling timely interventions and promoting optimal healing outcomes.
Reading the Signs: What Wound Exudate Is Trying to Tell You

Wound exudate is a natural byproduct of the body's inflammatory response to injury. When tissue is damaged, local blood vessels become more permeable, allowing a protein-rich fluid to seep into the interstitial space. This isn't random leakage; it's a purpose-built biological soup carrying everything the wound needs to heal effectively.
Inside that fluid, you'll find a host of critical components:
- White blood cells (Leukocytes): These are the cleanup crew, primarily neutrophils and macrophages, tasked with fighting off bacteria and removing dead tissue and cellular debris.
- Proteins and nutrients: Components like albumin, fibrinogen, and electrolytes act as the essential building blocks for new tissue formation (granulation).
- Growth factors and enzymes: These are the project managers, signaling cells to divide and directing the complex repair process. Key players include platelet-derived growth factor (PDGF) and matrix metalloproteinases (MMPs).
The Good, The Bad, and The Smelly
In the early stages of healing—the inflammatory phase—exudate is your friend. It maintains a moist wound bed, which is crucial for cell migration, autolytic debridement, and the overall wound healing process. A dry wound is a stalled wound, as cells cannot move across a desiccated surface.
However, the story changes as healing progresses through the proliferative and maturation phases. The type and amount of exudate should evolve. If it doesn't, or if it changes for the worse, that's a significant red flag. A sudden increase in volume, a shift from clear to opaque color, or the development of a foul odor can be the first indication of trouble, such as a brewing infection, tissue necrosis, or a systemic issue like malnutrition.
This is where assessment becomes an art. It's about more than just noting "drainage present." It's about translating what you see into smart clinical decisions—choosing the right dressing, justifying a change in treatment protocol, and catching complications before they derail the healing trajectory.
There are four main characters in the world of wound drainage: serous, sanguineous, serosanguinous, and purulent. Each one signals something different about the wound's status and the underlying physiology. Getting a handle on these is fundamental.
To make it easier, here’s a quick-reference table that breaks down what you'll typically see.
At-a-Glance Guide to Common Exudate Types
| Exudate Type | Appearance | Common Indication |
|---|---|---|
| Serous | Thin, clear, or pale yellow (like plasma) | Normal; common during the inflammatory stage of healing. A healthy sign of the body's initial response. |
| Sanguineous | Bright red, fresh blood | Indicates new bleeding from broken capillaries; seen in deep or fresh wounds, or after trauma/debridement. |
| Serosanguinous | Thin, watery, and pale red or pink | A mix of serous fluid and blood; typical in the early stages of healing, representing a transition from inflammation to proliferation. |
| Purulent | Thick, opaque, and tan, yellow, green, or brown | A strong sign of infection; contains a high concentration of white blood cells, bacteria, and cellular debris. |
This table is a great starting point. As we dive deeper, you'll learn to spot the nuances that separate a healthy, healing wound from one that needs immediate and decisive intervention. Recognizing these subtle shifts is what elevates a clinician's practice from routine to expert.
Getting to Know Serous and Sanguineous Exudate
Now that we've covered the basics of what exudate is, let's get into the two types you’ll see most often at the bedside: serous and sanguineous. These are the workhorses of the early healing stages, but knowing how to read their signals—like timing, volume, and context—is what separates a good assessment from a great one.
Serous Exudate: The Healing "Dew"
Think of serous exudate as the "dew" of a healing wound. It’s that thin, clear, or pale-yellow fluid that looks a lot like blood plasma. Seeing this is totally normal, especially during the initial inflammatory phase when the body is busy sending a rush of proteins and nutrients to the site to kickstart the repair process. A modest amount is expected and beneficial.
But here’s the key: the amount of serous fluid matters. A little bit is expected, but if you start seeing moderate to heavy amounts, it’s a sign that something else is going on. Excessive serous drainage often points to a high bioburden or underlying problems like venous insufficiency, which increases hydrostatic pressure and forces more fluid out of the vessels. In fact, systemic issues like malnutrition, which can lead to low serum albumin and contribute to heavy exudate, affect up to 60% of patients with chronic wounds.
For a deeper dive, you can learn more about how exudate quantity indicates underlying problems.
Sanguineous Exudate: Fresh Bleeding
Next up is sanguineous exudate, which is really just a clinical term for fresh blood. You’ll recognize it as bright red, watery drainage. This typically shows up when there's active bleeding, either from newly forming blood vessels (angiogenesis) during the proliferative phase or because the wound bed has been recently disturbed, like after a sharp debridement.
A little sanguineous drainage in a brand-new, deep wound is often just part of the deal. Context is everything, though. If you suddenly see fresh, bright red blood in a wound that's been healing for days or weeks, it’s a red flag. It could mean the wound was reinjured, or that the fragile new capillaries have been torn due to trauma, shear forces, or inappropriate dressing removal.
A crucial part of your assessment is telling the difference between expected bleeding and a sign of trouble. If you see consistent, bright red drainage that’s soaking through dressings quickly, that’s not normal. It could signal a hematoma or an eroded blood vessel, and it needs immediate attention.
Tips for Assessment and Documentation
Your notes are your best defense and the clearest way to communicate a wound’s status to the rest of the care team. When you’re documenting these common exudate types, go beyond just naming them. The real story is in the quantity and character. Precision here is non-negotiable for continuity of care.
Here’s a simple system for charting what you see:
- Scant: The wound tissue is moist, but there's no real measurable fluid on the dressing.
- Minimal/Small: Less than 25% of the dressing is saturated with fluid.
- Moderate: The dressing is between 25% and 75% saturated.
- Copious/Large: More than 75% of the dressing is saturated, and you might even see fluid coming through the outer layers (strikethrough).
A strong clinical note creates a clear picture for the next clinician. For instance: "Wound bed displays a minimal amount of serous exudate with intact peri-wound skin." This sets a perfect baseline. A more concerning note might read: "Moderate amount of sanguineous exudate noted after dressing change, an increase from scant serosanguinous noted yesterday."
Getting these descriptive terms right is a fundamental skill, and there are many wound assessment tools for nurses that can help you standardize your documentation. This level of detail is what ensures great continuity of care and backs up your clinical judgment.
Decoding Combination Types: Serosanguinous and Seropurulent
Once you get the hang of spotting basic serous and sanguineous fluids, you'll start noticing the in-between types. These mixtures can sometimes be tricky to identify, but they tell a very specific story about what’s happening inside the wound bed and whether things are on track or heading for trouble.
Serosanguinous Exudate: A Healthy Hybrid
Think of serosanguinous exudate as a good sign—it's progress you can see. This drainage is thin and watery, with a pale pink or light red color. It’s a simple mix of clear serous fluid and a small number of red blood cells that have leaked from newly forming capillaries, which are incredibly fragile during the proliferative stage of healing.
You’ll see this type of drainage all the time, especially right after a dressing change or during the early, active stages of healing. It’s a normal finding and tells you the wound is healing just as it should. It signifies that the inflammatory phase is winding down and the rebuilding phase is beginning.
The key is to watch the trend. The drainage should gradually become clearer over a few days, transitioning from serosanguinous back to scant serous. If it starts looking redder instead, that's a clue. It could mean the delicate new tissue is being reinjured, maybe from too much movement, pressure, or the wrong type of dressing creating friction.
Seropurulent Exudate: The Early Warning System
While serosanguinous fluid is reassuring, seropurulent exudate is the complete opposite. It's a critical red flag that needs your immediate attention. This drainage is still thin and watery, but it has a cloudy, milky look to it, sometimes with a subtle yellow or tan tinge. This is one of the very first signs of a brewing infection, indicating an increasing bioburden that the body is struggling to control.
Think of seropurulent exudate as the smoke before the fire. It’s not thick, obvious pus just yet, but it’s a clear signal that the body is dispatching a higher number of white blood cells to fight off invading bacteria. Ignoring it is like waiting for the flames to appear before you call for help.
That shift from clear serous fluid to a cloudy or milky appearance is your cue. It’s a visual confirmation that an immune response is underway. Misidentifying this can delay crucial antimicrobial treatments, which can derail healing timelines in up to 45% of chronic wounds that show these early infectious signs. For a deeper dive, you can discover more insights about wound exudate on Woundsource.com.
When you spot seropurulent drainage, it’s time to switch into high-alert mode. Start looking for other subtle signs of infection that often accompany it, known as the classic signs of localized infection:
- New or Worsening Odor: You might notice a faint, unpleasant smell that wasn't there before.
- Increased Erythema: The redness around the wound might start to spread or look angrier.
- Localized Warmth: The skin immediately surrounding the wound may feel warmer than the other skin.
- Increased Pain: The patient may report a new or increasing level of pain at the wound site.
Knowing how to read these combination exudates is a fundamental skill. One signals healthy progress, and the other is a clear call to action. Making the right call allows you to step in, adjust the plan of care, and stop a potential complication in its tracks.
Purulent Exudate: The Unmistakable Sign of Infection

When you see purulent exudate, the wound is screaming for help. This isn't a subtle hint; it's a clear, urgent signal of infection. Unlike the other exudate types, purulent drainage is never a normal finding in a healing wound. It’s the single most critical red flag you’ll encounter, and it demands immediate action.
Commonly known as pus, this type of drainage looks distinctly unhealthy. It's typically thick, opaque, and milky, a world away from the thin, clear, or reddish fluids we see in a clean, healing wound bed. Its viscosity is a key characteristic.
Identifying Purulent Exudate By Sight and Smell
The look and smell of purulent drainage are more than just unpleasant—they're valuable diagnostic clues. These characteristics can give you a pretty good idea of the specific bacteria wreaking havoc, helping to guide the initial treatment strategy long before lab results come back.
The color, for instance, can tell a story:
- Yellow or Tan: This is often the calling card of Staphylococcus aureus, one of the most common culprits in wound infections.
- Green: Think Pseudomonas aeruginosa. This classic sign is frequently paired with a sickly sweet, almost grape-like odor that's hard to forget once you've smelled it.
- Brown or Gray: This may point to a more complex situation, like a polymicrobial infection where several different bacteria are involved. It often carries a strong, fecal-like odor, especially if Proteus species are present.
The smell is another dead giveaway. While many chronic wounds have a certain odor from bacteria and necrotic tissue, the foul smell of an infected wound is potent and persistent. It clings to the air even right after you’ve cleaned the wound.
This thick, colored drainage is essentially the aftermath of a microscopic battle. The body has dispatched an army of white blood cells (leukocytes) to fight off the invading pathogens. The pus you see is composed of the casualties: dead white blood cells, dead bacteria, and bits of tissue debris. This is a key distinction, and it's important to understand if pus is always a sign of infection and what it means for the patient.
Interpreting Purulent Exudate Color and Pathogens
The color of purulent drainage isn't just a random characteristic; it's a window into the wound's microbiology. By observing the specific hue and any associated odors, clinicians can make an educated guess about the likely pathogen, which can be invaluable while waiting for culture results to confirm.
| Color/Odor | Potential Pathogen | Clinical Notes |
|---|---|---|
| Creamy Yellow/Tan | Staphylococcus aureus | The most common presentation. Can range from thin to thick consistency. Odor is typically not overly foul. |
| Greenish-Blue | Pseudomonas aeruginosa | Often has a characteristic sweet, grape-like, or "fruity" odor. The drainage can stain dressings green. |
| Brownish-Red | Proteus species | Frequently has a strong, foul, or fecal-like odor. Common in wounds contaminated with gastrointestinal flora. |
| Grayish | Anaerobic bacteria (e.g.,Streptococcus) | May indicate a mixed or anaerobic infection. Often accompanied by a significant, putrid smell. |
This table is a practical starting point, not a definitive diagnostic tool. Always rely on a laboratory culture for precise identification and antibiotic susceptibility testing.
Your Action Plan For Purulent Drainage
Spotting purulent exudate is only the first step. Your response must be swift and systematic to stop the infection from spreading, which could lead to severe tissue damage or even a systemic illness like sepsis.
If you confirm purulent drainage, here's what needs to happen next:
- Notify the Provider Immediately: This is non-negotiable. Purulent drainage means the current treatment plan has failed, and a new one involving antimicrobial therapy is almost always necessary.
- Get a Wound Culture: Before starting any new topical or systemic antibiotics, collect a culture specimen using a standardized technique like the Levine method. This is crucial for identifying the exact pathogen and figuring out which antibiotics will be most effective.
- Start Aggressive Wound Care: The focus shifts to getting the infection under control. This involves thorough cleansing and often debridement to physically remove the pus and infected tissue, followed by antimicrobial dressings to fight bacteria directly in the wound.
- Document Everything Meticulously: Chart the color, consistency, amount, and odor of the drainage. Also, note any other signs of infection—is there more pain? Is the surrounding skin red, swollen, or warm to the touch? This detailed record is essential for tracking how well the treatment is working.
Matching Dressings to Exudate Types

Identifying the type of exudate is just the first half of the puzzle; the real skill lies in knowing what to do about it. The goal isn't to stop the fluid entirely—it’s an essential part of healing—but to manage it. We're aiming for that sweet spot: a perfectly balanced, moist environment where the wound can heal without turning the surrounding skin into a soggy, damaged mess.
Think of yourself as a gardener tending to a delicate plant. Too little water, and the soil cracks and the plant withers. Too much, and the roots will rot. The wound bed is your garden, and the dressing is your irrigation system. It has to be just right.
Strategies for Low Exudate Wounds
When you see a wound with only scant or minimal serous fluid, your biggest enemy is dehydration. A dry wound bed is like a roadblock for healing. New cells simply can't migrate across a dry surface to close the gap. Your job here is to preserve every drop of moisture, or even add a little more.
For these situations, reach for dressings designed to hydrate:
- Hydrogels: These are fantastic because they actively donate moisture. Think of them as a drink of water for a thirsty wound bed, making them perfect for those dry or minimally draining wounds.
- Transparent Films: These are like a greenhouse for the wound. They're non-absorbent and simply trap the wound's own moisture, maintaining a natural balance while letting you keep an eye on things without disturbing the dressing.
- Hydrocolloids: These are a great choice for wounds with minimal to light drainage. They interact with the fluid to create a soft gel, forming a protective, moist cushion over the wound bed.
Managing Moderate to Heavy Exudate
Now, let's flip to the other side of the coin. For wounds with moderate to heavy drainage—like those with lots of serous fluid or any amount of purulent discharge—the challenge is absorption. You have to get that excess fluid away from the skin before it causes maceration, which is the softening and breakdown of tissue that can make the wound bigger and open the door to infection.
Choosing the right dressing is everything here. A product like alginate can absorb up to 20 times its own weight in fluid, making it a workhorse for heavily draining wounds. But if you put that same powerful dressing on a dry wound, you'd suck the life right out of it and stall healing. This principle of moisture balance is a cornerstone of modern wound care, influencing over 80% of our dressing choices. You can dive deeper into these principles by reading the best practices in exudate management on WoundsInternational.com.
The key is to match the dressing's absorbency to the wound's output. The right dressing should absorb excess fluid from the wound bed without drying it out, while also protecting the peri-wound skin from moisture damage.
For wounds that produce a lot of fluid, these are your go-to options:
- Foams: A versatile and popular choice. They do a great job of soaking up moderate to heavy exudate while also providing a soft, protective cushion over the wound.
- Alginates and Hydrofibers: Derived from natural sources like seaweed, these dressings are incredible. They transform into a gel as they absorb fluid, which makes them ideal for packing deep, heavily draining wounds and cavities.
- Superabsorbent Dressings: When you're facing extreme amounts of exudate, these are your heavy hitters. They have multiple layers designed to pull in and lock away massive volumes of fluid, keeping the skin as dry as possible.
Remember, choosing a dressing isn't a one-and-done decision. A wound is a dynamic environment. As the types of exudates and the amount of drainage change, your management strategy has to change with it. Constant reassessment is the only way to ensure the wound always has exactly what it needs to heal.
Recognizing Hemorrhagic and Chylous Exudates
Once you've mastered the basics, it's time to look for the outliers. While most wounds present with serous, sanguineous, or purulent fluid, two other types of drainage can appear: hemorrhagic and chylous.
These aren't your everyday findings. In fact, they’re major red flags signaling that something more serious is going on beneath the surface. Being able to spot them is a hallmark of an advanced wound care clinician.
Hemorrhagic Exudate: More Than Just a Little Blood
You might be thinking, "Isn't this the same as sanguineous?" Not quite. While both involve blood, hemorrhagic exudate is frank, bright red bleeding. Think of sanguineous drainage as blood thinned out with plasma; hemorrhagic is the real deal, indicating an active, ongoing bleed that is copious and difficult to control.
Seeing this type of drainage means a blood vessel has been damaged or has eroded. It’s a sign that you need to act fast.
The cause could be anything from recent, severe trauma to a clotting disorder (coagulopathy). In more sinister cases, it might point to an infection that has eroded a vessel, a friable tumor, or a fistula connecting to a major artery. This isn't a "wait and see" situation—it demands immediate attention and may constitute a medical emergency. To learn more, check out this guide on the essentials of wound exudate on clinimed.co.uk.
Chylous Exudate: A Leak in the Lymphatic System
Now for a truly rare one: chylous exudate. If you see this, you won't forget it. The drainage is a distinct, milky-white color, often with a high-fat content that feels greasy.
This unusual fluid comes from a disruption to the body's lymphatic system, most often the thoracic duct. Think of the lymphatic network as a second, parallel circulatory system that transports a fatty fluid called chyle from the small intestine back to the bloodstream. When one of its main "pipelines" is damaged, this chyle leaks out into a wound or body cavity.
The appearance of chylous exudate is a clear sign of a significant internal injury or pathology. It's often linked to thoracic surgery, major chest trauma, or a tumor eroding a lymphatic duct. It is never a normal finding in a wound.
What to Do Next: Management and Response
Identifying these exudates is only the first step. Your response has to be just as specialized and swift.
- For Hemorrhagic Exudate: Your number one priority is to stop the bleeding—a concept known as hemostasis. This could mean applying direct pressure, using specialized hemostatic dressings (like those containing alginate or chitosan), or, if the bleed is severe, escalating to a physician for possible surgical repair or vascular intervention. At the same time, the underlying cause must be found and addressed.
- For Chylous Exudate: The goal here is to reduce or stop the flow of lymphatic fluid. Management often involves a team approach, including dietary changes (like a very low-fat diet and use of medium-chain triglycerides) to decrease chyle production. In many cases, surgical intervention is needed to tie off the leaking duct. This is a complex problem that requires specialized medical and surgical management.
Your Top Questions About Wound Exudate Answered
Let's be honest, figuring out wound exudate at the bedside can bring up some tricky situations. Here are some clear, no-nonsense answers to the questions I hear most often from fellow clinicians.
How Do I Actually Document the Amount of Drainage?
Getting the documentation right is about painting a clear picture for the next person. Vague terms don't help anyone. Instead of just guessing, we use a pretty standard scale to describe not just how much drainage there is, but what it looks like. This provides an objective measure that can be tracked over time.
Here's how to chart the amount:
- Scant: The wound bed is moist, but there's really no measurable drainage on the dressing itself.
- Minimal: A small amount of fluid is visible, covering less than 25% of the dressing.
- Moderate: The drainage has saturated between 25% and 75% of the dressing.
- Copious: This is a lot of fluid. The dressing is soaked through more than 75%, and you might even see "strikethrough" where it has leaked through to the outer layer.
The key is to combine the amount with the type. For instance, you might chart: "Moderate amount of thin, serosanguinous exudate noted on primary dressing. Peri-wound skin remains intact." That one sentence tells a detailed story and justifies your choice of dressing.
Can One Wound Have Different Kinds of Exudate?
Absolutely. It's actually pretty common, especially with larger or more complex wounds. Think of it as a wound with different "neighborhoods." You might see some nasty purulent drainage in one corner hinting at a localized infection, while another area is producing that nice, healthy serosanguinous fluid we like to see.
When this happens, you have to chart what you see in each specific area. A useful technique is the "clock method," where you describe the findings based on their position (e.g., "purulent exudate noted at the 3 o'clock position"). This lets you create a targeted treatment plan. For example, you could apply a small antimicrobial dressing to just the infected spot while using a simple absorbent dressing on the rest.
This kind of specific, zonal assessment is what separates good wound care from great wound care. If you treat the whole wound based on its worst part, you could actually damage the healthy tissue that's trying to heal. Documenting by zone ensures every part of the wound gets exactly what it needs.
When Should a Sudden Change in Drainage Worry Me?
Any abrupt change is a major red flag. It’s the wound’s way of screaming that something significant has changed in its environment. A wound that was on a positive healing trajectory does not suddenly decline without a reason.
Be on high alert for these signs:
- A sudden jump in volume (e.g., a wound that was almost dry yesterday is now draining copiously). This could indicate a new infection or fluid collection.
- A change in color and consistency to thick purulent or bright red hemorrhagic exudate. This points to infection or active bleeding.
- A new, foul odor that doesn’t go away even after you've cleaned the wound. This is highly suggestive of a new or worsening infection, particularly with anaerobic bacteria.
These aren't just minor shifts; they often point to a new infection, a bleeding vessel, or a rapid decline in the tissue. This is when you need to get the primary provider involved immediately to rethink the plan of care, obtain new orders, and potentially prevent a severe complication.
At Ekagra Health AI, we know that precise assessment is the bedrock of effective wound care. Our AI-powered platform helps you capture detailed notes and measurements effortlessly, then generates your structured charts automatically. This can cut documentation time by up to 70%, freeing you up to focus on your patients. See how our "voice to claim" system can bring your documentation, coding, and billing together seamlessly at https://ekagrahealth.ai.

